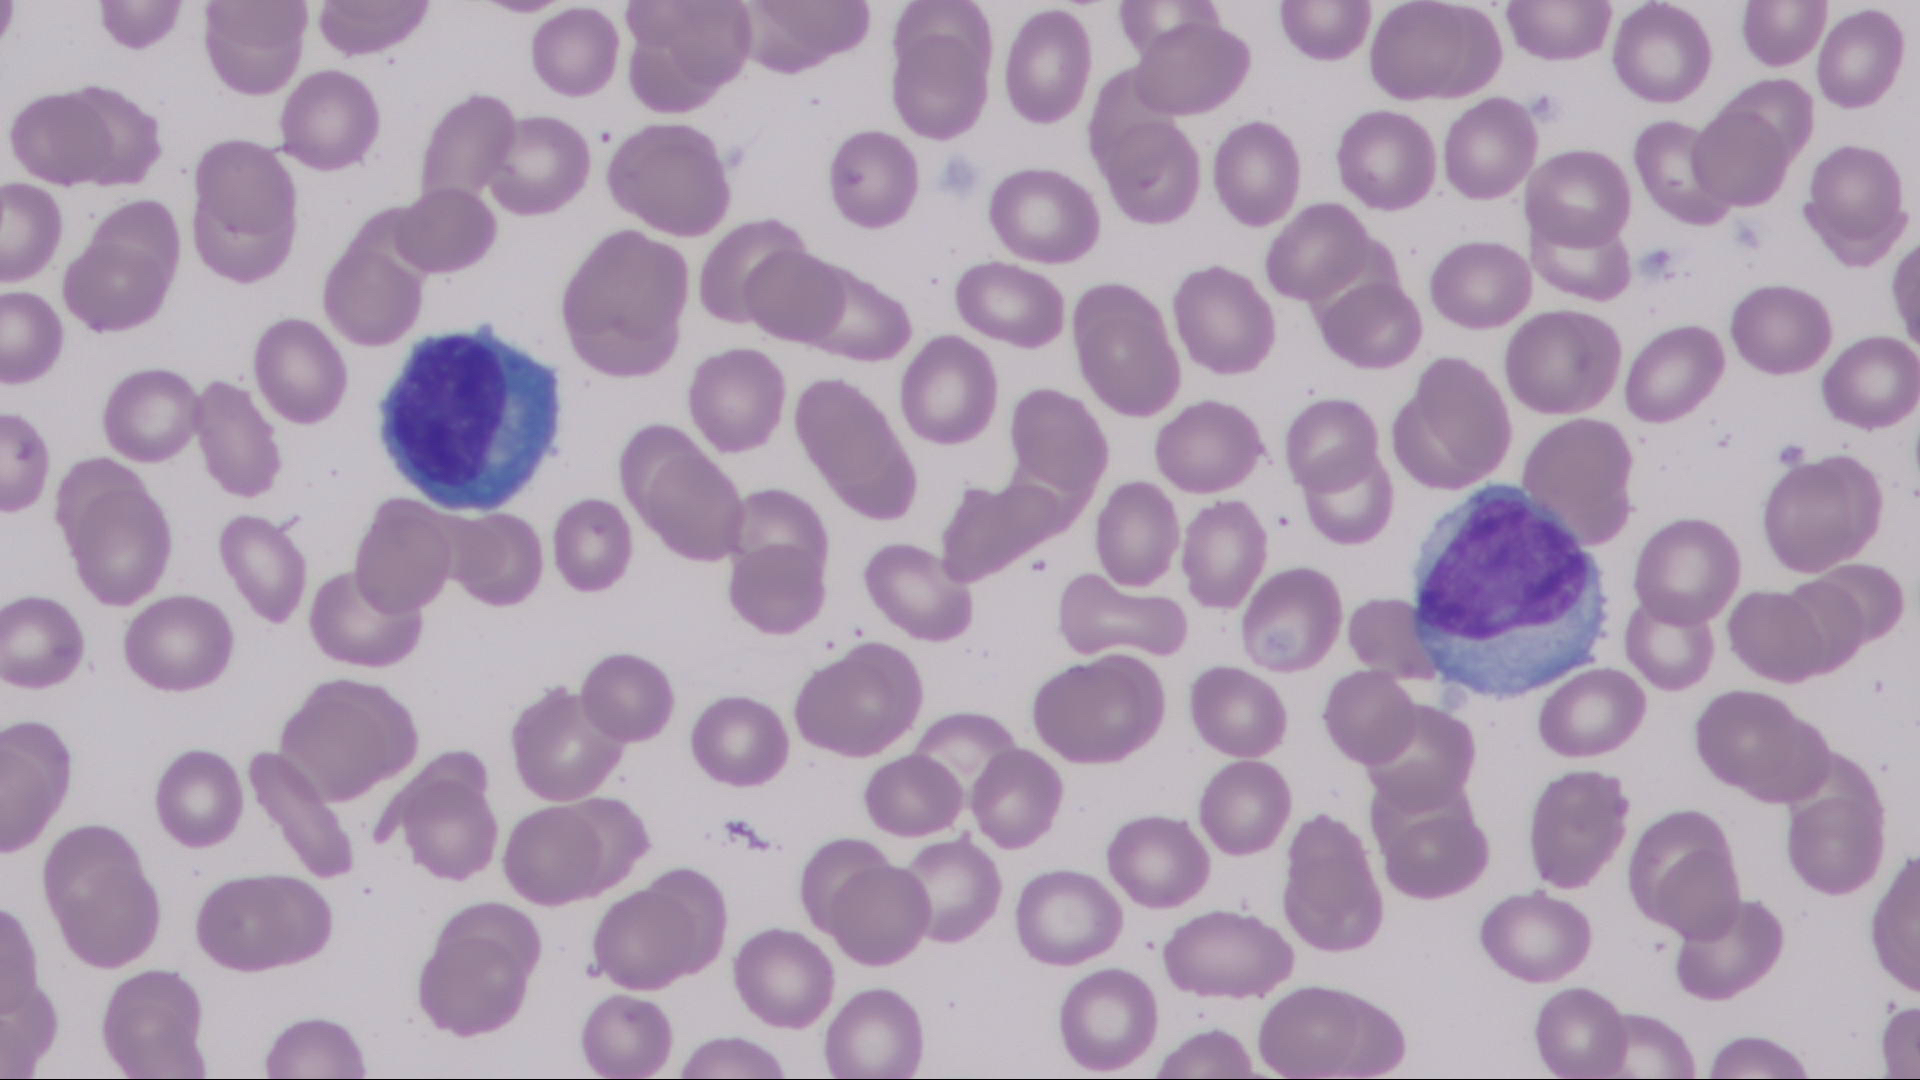

Case Presentation: A 61-year-old man presented to the emergency department with acute onset of fevers, myalgias and generalized erythematous rash after taking five weeks of Trimethoprim-sulfamethoxazole (TMP-SMX) for acute prostatitis. Vital signs were notable for fever and tachycardia, with relative hypotension which responded to initial fluid resuscitation. The patient initially denied abdominal pain however the lipase was elevated above 800, and a computed tomography of the abdomen revealed findings consistent with acute pancreatitis. Laboratory data showed acute kidney injury, elevated transaminases, normal leukocyte count, absence of eosinophils, but presence of atypical lymphocytes. The patient was admitted to the general medicine service, and within six hours the patient developed facial swelling and worsening generalized erythema. Due to concern for severe infection, the patient was started empirically on broad spectrum antibiotics. However, after no discernible clinical improvement with antibiotic therapy, and given the generalized erythema, TMP-SMX toxicity was suspected and dermatology was consulted. A scoring system called The European Registry of Severe Cutaneous Adverse Reactions (RegiSCAR), based on clinical and objective data, was used to diagnose Drug reaction with eosinophilia and systemic symptoms (DRESS) syndrome. The patient was started on high dose steroids, with improvement in clinical status overall, but on hospital day two did develop epigastric pain radiating to the back, nausea, and vomiting. He was treated for acute pancreatitis, and other etiologies of pancreatitis were excluded. On hospital day five the lipase, transaminases, and creatinine trended towards normal and he was discharged with a six week prednisone taper, and TMP-SMX was marked as an allergy in the patient’s medical record.
Discussion: DRESS syndrome is a rare and potentially life-threatening condition with an annual incidence of 0.9 in 100,000. It occurs between two to six weeks after initiation of the offending medication, and is commonly seen with anticonvulsants, such as carbamazepine (27 percent of reported cases), but also with antibiotics such as TMP-SMX (1 percent of reported cases). DRESS syndrome is characterized by rash, fever to greater than 38.8 degrees Celsius, lymphadenopathy, facial edema, and visceral organ involvement. This case describes the uncommon association between TMP-SMX induced DRESS syndrome and acute pancreatitis, and demonstrates that eosinophilia is not required for diagnosis.
Conclusions: This case illustrates three main points that hospitalists should know about DRESS syndrome. First, acute pancreatitis is a significant but rare type of visceral organ involvement in DRESS syndrome, and is only reported in a handful of case reports. The most commonly involved organs are kidneys and liver. Second, eosinophilia is not required to diagnose DRESS syndrome, and is only present in 66% of cases. However, presence of atypical lymphocytes is a diagnostic criterion and is found in 27% of cases. Third, the hospitalist should be aware that DRESS syndrome can mimic sepsis in its initial presentation, and should consider DRESS syndrome in the differential diagnosis in patients with high fever with rash.